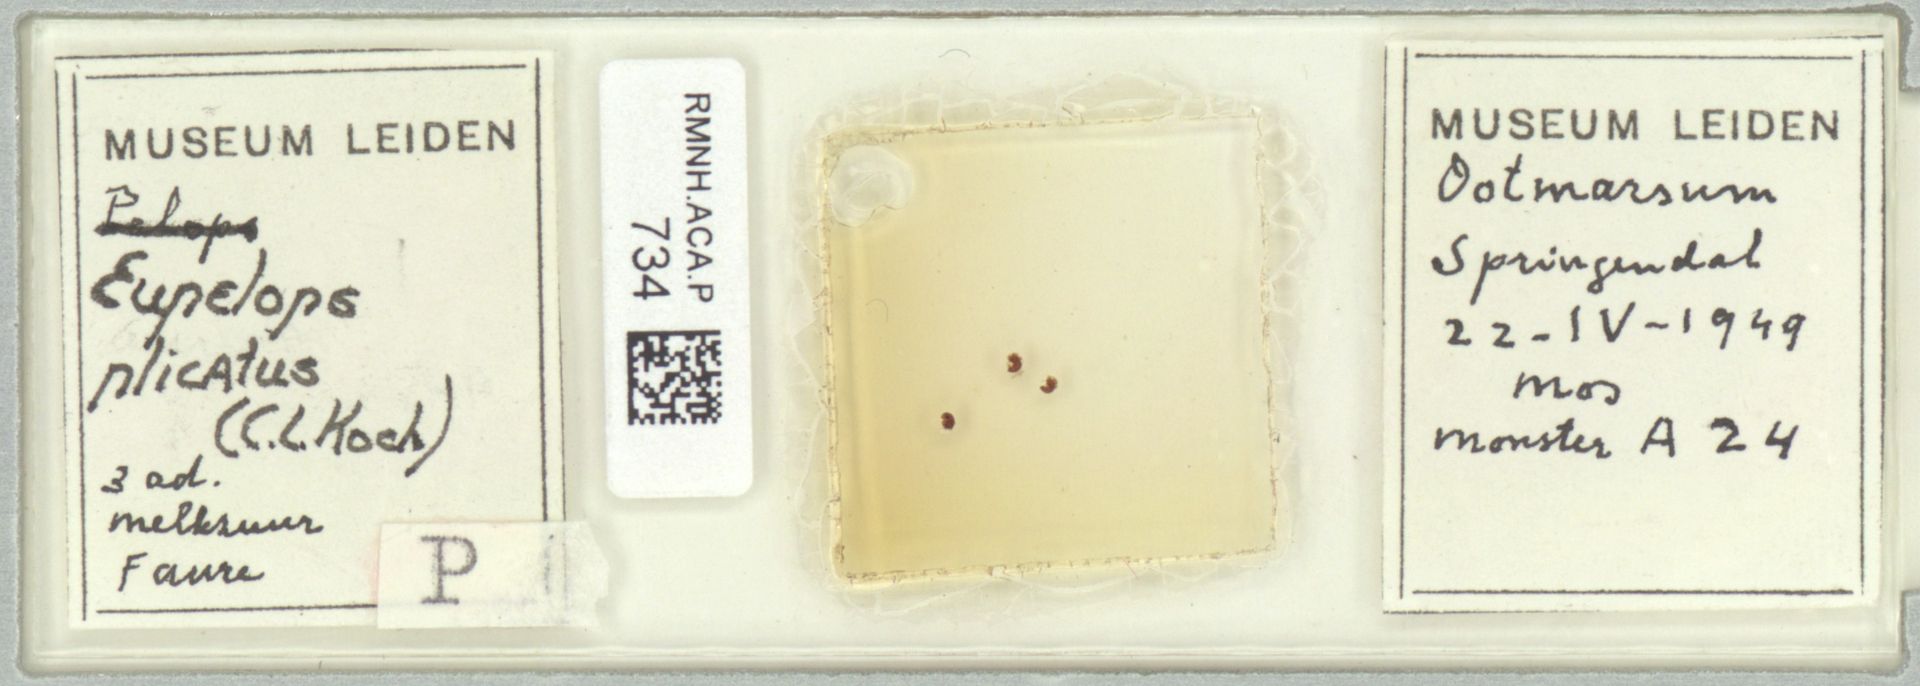

Espèces 1633 à 1648 sur 2271
Oribatula tibialis
Nicolet, 1855
44 occurrences
44 medias

Phauloppia lucorum
C.L. Koch, 1841
18 occurrences
18 medias

Zygoribatula exilis
Nicolet, 1855
15 occurrences
15 medias

Zygoribatula frisiae
Oudemans, 1900
4 occurrences
4 medias

Oribotritia berlesei
Michael, 1898
8 occurrences
8 medias

Eupelops acromios
Hermann, 1804
9 occurrences
9 medias

Eupelops bilobus
Sellnick, 1928
2 occurrences
2 medias

Eupelops duplex
Berlese, 1916
2 occurrences
2 medias

Eupelops plicatus
C. L. Koch, 1835
27 occurrences
27 medias
Phthiracarus anonymum
Grandjean, 1933
1 occurrences
1 medias

Phthiracarus crinitus
C.L. Koch, 1841
5 occurrences
5 medias

Phthiracarus ferrugineus
C. L. Koch, 1841
2 occurrences
2 medias

Phthiracarus laevigatus
C.L. Koch, 1841
3 occurrences
3 medias

Phthiracarus longulus
C.L. Koch, 1841
4 occurrences
4 medias

Phthiracarus stramineus
C. L. Koch, 1841
1 occurrences
1 medias

Proctophyllodes anthi
Vitzthum, 1922
82 occurrences
82 medias
